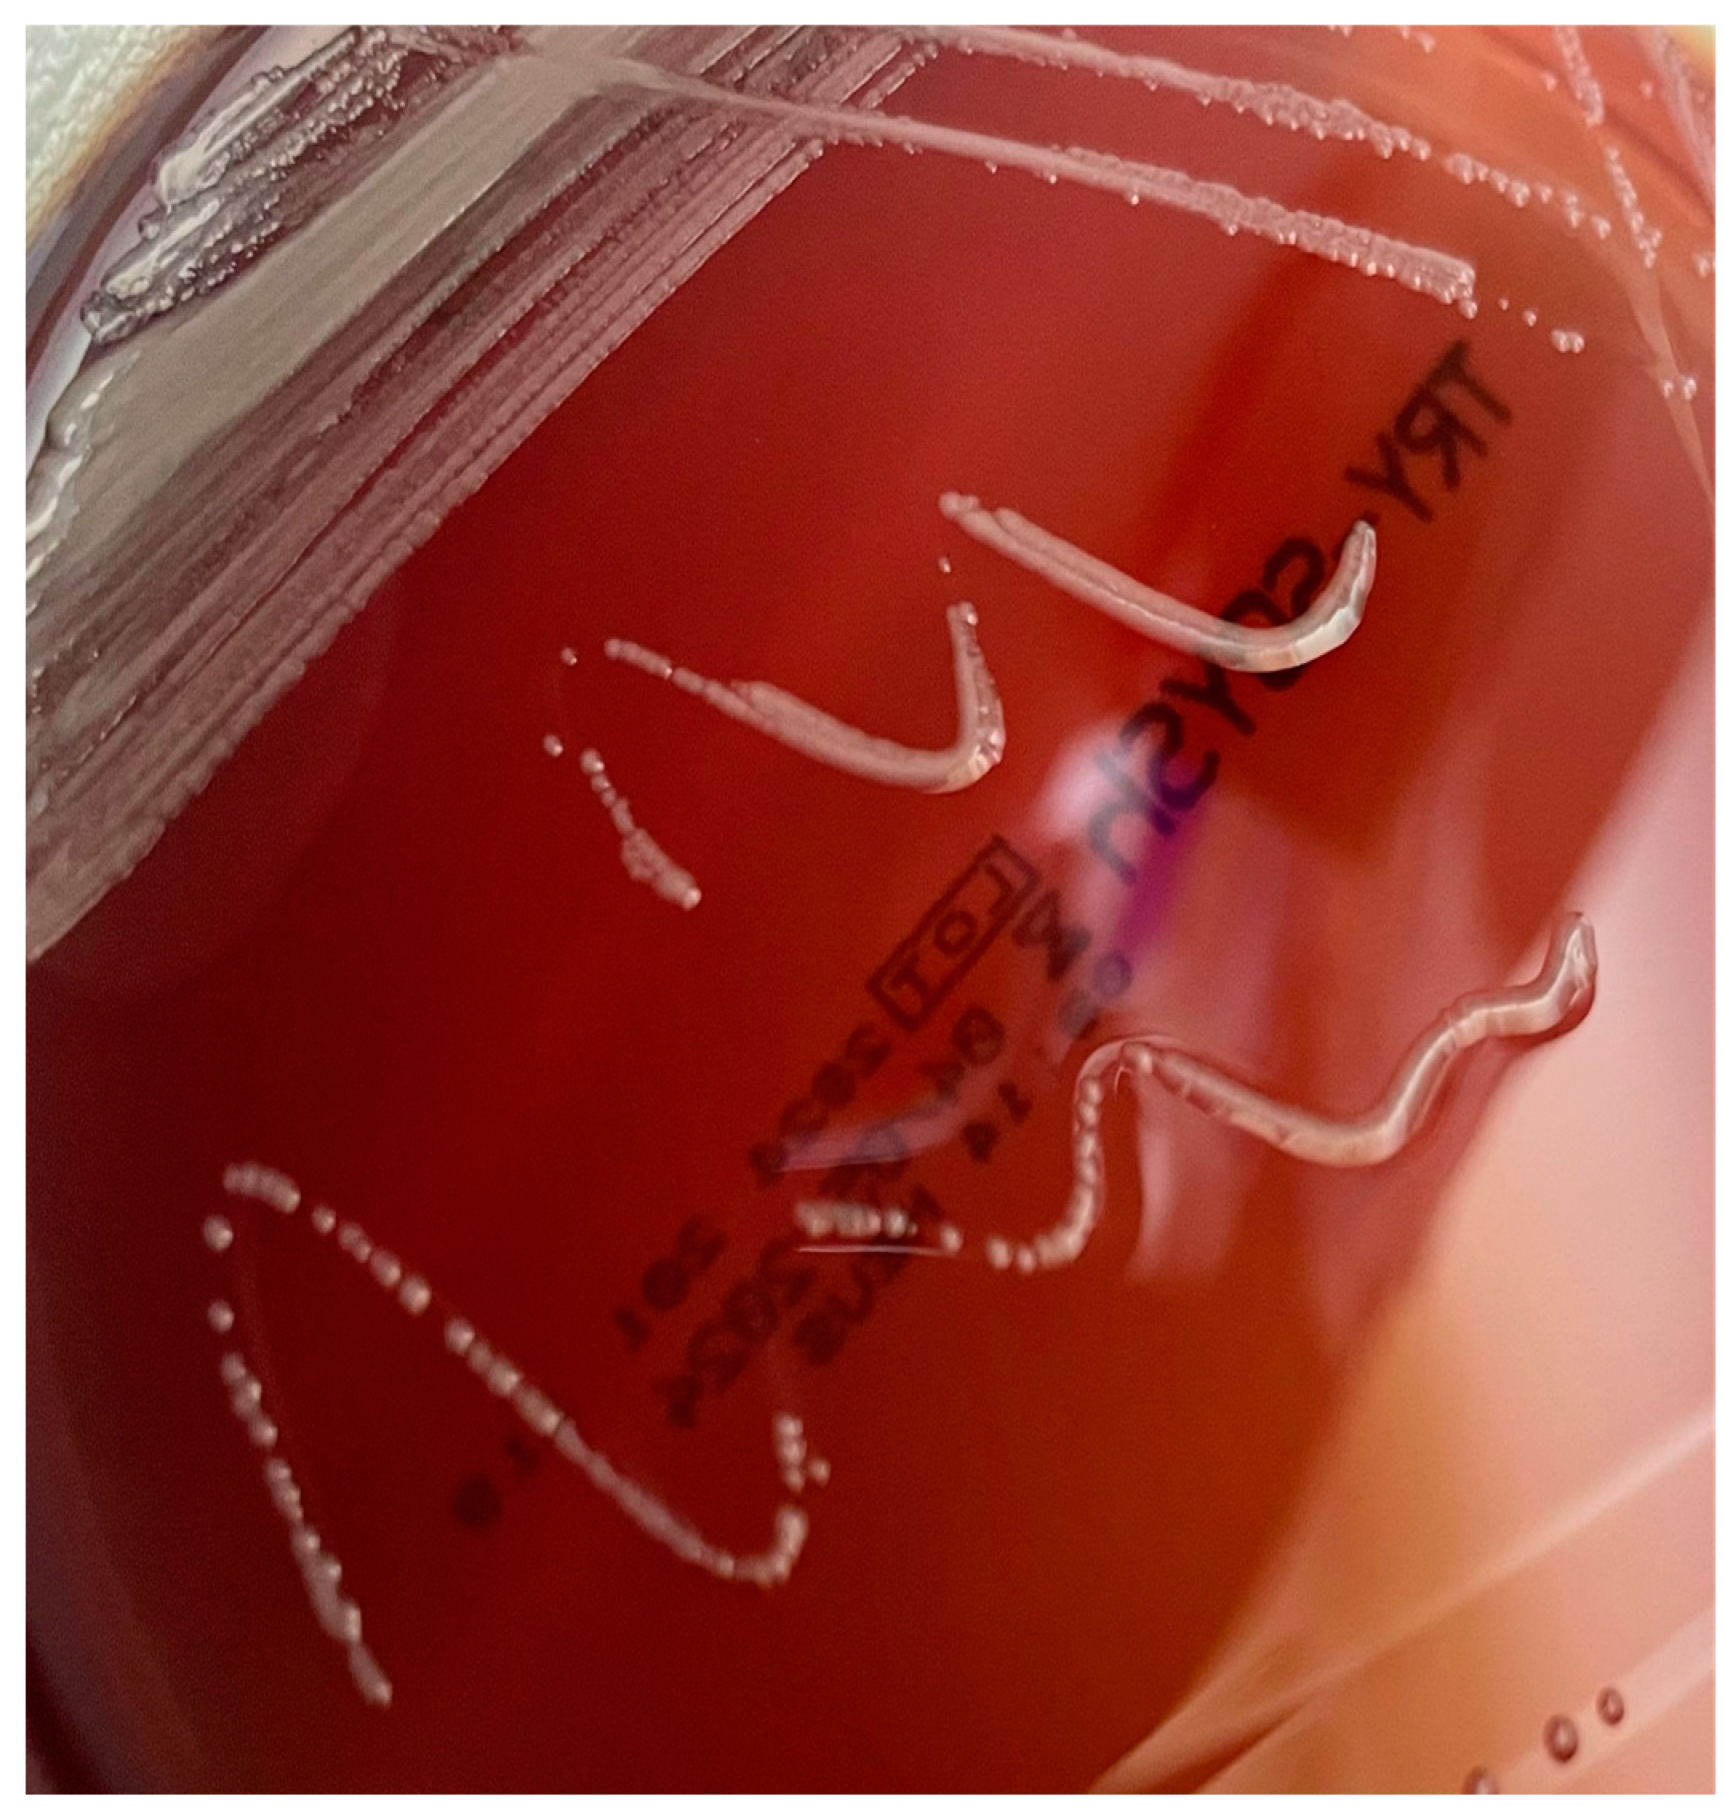
Antibiotics 14 00306 g005

Rare or Unusual Non-Fermenting Gram-Negative Bacteria: Therapeutic Approach and Antibiotic Treatment Options
Abstract
1. Introduction
2. Taxonomy and Microbiology
2.1. General Characteristics and Microbiological Diagnosis
2.2. Taxonomy
2.3. Virulence Factors, Role of the Biofilm and General Consideration on Antibiotic Resistance
3. Achromobacter
4. Alcaligenes
5. Burkholderia
6. Elizabethkingia
7. Moraxella
8. Other Rare Non-Fermenting Gram-Negative Bacteria
9. Discussion
10. Materials and Methods
11. Conclusions
Author Contributions
Funding
Institutional Review Board Statement
Informed Consent Statement
Data Availability Statement
Conflicts of Interest
Abbreviations
| ABSSI | acute bacterial skin and skin structure infection |
| A/C | amoxicillin–clavulanic acid |
| AMG | aminoglycoside |
| AMK | amikacin |
| AST | antimicrobial susceptibility testing |
| AZT | aztreonam |
| Bcc | B. cepacia complex |
| BL/BLI | β-lactam/β-lactamase inhibitor |
| Bpc | B. pseudomallei complex |
| BSI | bloodstream infection |
| CAZ | ceftazidime |
| CDC | Centers for Disease Control and Prevention |
| C/A | ceftazidime–avibactam |
| CLSI | Clinical and Laboratory Standards Institute |
| CRP | C-reactive protein |
| C/T | ceftolozane–tazobactam |
| DELA | delafloxacin |
| DOXI | doxycycline |
| ESBL | extended-spectrum β-lactamase |
| EUCAST | European Committee on Antimicrobial Susceptibility Testing |
| FEP | cefepime |
| FDC | cefiderocol |
| FQ | fluoroquinolone |
| GNT | gentamicin |
| ICU | intensive care unit |
| IMP | imipenem |
| LPS | lipopolysaccharide |
| MALDI-TOF | matrix-assisted laser desorption/ionization time of flight |
| MBL | metallo-β-lactamase |
| MDR | multidrug-resistant |
| MEM | meropenem |
| M/V | meropenem–vaborbactam |
| MIC | minimum inhibitory concentration |
| MIN | Minocycline |
| MOXI | Moxifloxacin |
| NFGNB | non-fermenting Gram-negative bacteria |
| OXA | oxacillinase |
| PCR | polymerase chain reaction |
| P/T | piperacillin–tazobactam |
| TET | tetracycline |
| TG | tigecycline |
| UTI | urinary tract infection |
| XDR | extensively drug-resistant |
References
- Enoch, D.A.; Birkett, C.I.; Ludlam, H.A. Non-Fermentative Gram-Negative Bacteria. Int. J. Antimicrob. Agents 2007, 29, S33–S41. [Google Scholar] [CrossRef] [PubMed]
- Di Pilato, V.; Willison, E.; Marchese, A. The Microbiology and Pathogenesis of Nonfermenting Gram-Negative Infections. Curr. Opin. Infect. Dis. 2023, 36, 537–544. [Google Scholar] [CrossRef] [PubMed]
- Behzadi, P.; Baráth, Z.; Gajdács, M. It’s Not Easy Being Green: A Narrative Review on the Microbiology, Virulence and Therapeutic Prospects of Multidrug-Resistant Pseudomonas Aeruginosa. Antibiotics 2021, 10, 42. [Google Scholar] [CrossRef]
- Giovagnorio, F.; De Vito, A.; Madeddu, G.; Parisi, S.G.; Geremia, N. Resistance in Pseudomonas Aeruginosa: A Narrative Review of Antibiogram Interpretation and Emerging Treatments. Antibiotics 2023, 12, 1621. [Google Scholar] [CrossRef] [PubMed]
- Casale, R.; Boattini, M.; Comini, S.; Bastos, P.; Corcione, S.; De Rosa, F.G.; Bianco, G.; Costa, C. Clinical and Microbiological Features of Positive Blood Culture Episodes Caused by Non-Fermenting Gram-Negative Bacilli Other than Pseudomonas and Acinetobacter Species (2020–2023). Infection 2024, 53, 183–196. [Google Scholar] [CrossRef]
- Yadav, S.K.; Bhujel, R.; Mishra, S.K.; Sharma, S.; Sherchand, J.B. Emergence of Multidrug-Resistant Non-Fermentative Gram Negative Bacterial Infection in Hospitalized Patients in a Tertiary Care Center of Nepal. BMC Res. Notes 2020, 13, 319. [Google Scholar] [CrossRef]
- Mojica, M.F.; Humphries, R.; Lipuma, J.J.; Mathers, A.J.; Rao, G.G.; Shelburne, S.A.; Fouts, D.E.; Van Duin, D.; Bonomo, R.A. Clinical Challenges Treating Stenotrophomonas Maltophilia Infections: An Update. JAC Antimicrob. Resist. 2022, 4, dlac040. [Google Scholar] [CrossRef]
- Rattanaumpawan, P.; Ussavasodhi, P.; Kiratisin, P.; Aswapokee, N. Epidemiology of Bacteremia Caused by Uncommon Non-Fermentative Gram-Negative Bacteria. BMC Infect. Dis. 2013, 13, 167. [Google Scholar] [CrossRef]
- Rivera-Villegas, H.O.; Martinez-Guerra, B.A.; Garcia-Couturier, R.; Xancal-Salvador, L.F.; Esteban-Kenel, V.; Jaimes-Aquino, R.A.; Mendoza-Rojas, M.; Cervantes-Sánchez, A.; Méndez-Ramos, S.; Alonso-Montoya, J.E.; et al. Predictors of Mortality in Patients with Infections Due to Carbapenem-Resistant Gram-Negative Bacteria. Antibiotics 2023, 12, 1130. [Google Scholar] [CrossRef]
- Zheng, G.; Wang, S.; Lv, H.; Zhang, G. Nomogram Analysis of Clinical Characteristics and Mortality Risk Factor of Non-Fermentative Gram-Negative Bacteria-Induced Post-Neurosurgical Meningitis. Infect. Drug Resist. 2022, 15, 6379–6389. [Google Scholar] [CrossRef]
- Jean, S.-S.; Gould, I.M.; Lee, W.-S.; Hsueh, P.-R. International Society of Antimicrobial Chemotherapy (ISAC) New Drugs for Multidrug-Resistant Gram-Negative Organisms: Time for Stewardship. Drugs 2019, 79, 705–714. [Google Scholar] [CrossRef] [PubMed]
- Chumbita, M.; Monzo-Gallo, P.; Lopera-Mármol, C.; Aiello, T.F.; Puerta-Alcalde, P.; Garcia-Vidal, C. New Treatments for Multidrug-Resistant Non-Fermenting Gram-Negative Bacilli Infections. Rev. Esp. Quimioter. 2022, 35 (Suppl. S3), 51–53. [Google Scholar] [CrossRef] [PubMed]
- Giacobbe, D.R.; Labate, L.; Russo Artimagnella, C.; Marelli, C.; Signori, A.; Di Pilato, V.; Aldieri, C.; Bandera, A.; Briano, F.; Cacopardo, B.; et al. Use of Cefiderocol in Adult Patients: Descriptive Analysis from a Prospective, Multicenter, Cohort Study. Infect. Dis. Ther. 2024, 13, 1929–1948. [Google Scholar] [CrossRef] [PubMed]
- Hoellinger, B.; Simand, C.; Jeannot, K.; Garijo, C.; Cristinar, M.; Reisz, F.; Danion, F.; Ursenbach, A.; Lefebvre, N.; Boyer, P.; et al. Real-World Clinical Outcome of Cefiderocol for Treatment of Multidrug-Resistant Non-Fermenting, Gram Negative Bacilli Infections: A Case Series. Clin. Microbiol. Infect. 2023, 29, 393–395. [Google Scholar] [CrossRef]
- Chawla, K.; Vishwanath, S.; Munim, F.C. Nonfermenting Gram-Negative Bacilli Other than Pseudomonas Aeruginosa and Acinetobacter Spp. Causing Respiratory Tract Infections in a Tertiary Care Center. J. Glob. Infect. Dis. 2013, 5, 144–148. [Google Scholar] [CrossRef]
- Murray, P.R.; Rosenthal, K.S.; Pfaller, M.A. Medical Microbiology; Elsevier Health Sciences: Amsterdam, The Netherlands, 2020; ISBN 978-0-323-67450-8. [Google Scholar]
- Procop, G.W.; Church, D.L.; Hall, G.S.; Janda, W.M.; Koneman, E.W.; Schreckenberger, P.; Woods, G.L. Koneman’s Color Atlas and Textbook of Diagnostic Microbiology, 7th ed.; Wolters Kluwer Health: Philadelphia, PA, USA, 2017; ISBN 978-1-4511-1659-5. [Google Scholar]
- Whistler, T.; Sangwichian, O.; Jorakate, P.; Sawatwong, P.; Surin, U.; Piralam, B.; Thamthitiwat, S.; Promkong, C.; Peruski, L. Identification of Gram Negative Non-Fermentative Bacteria: How Hard Can It Be? PLoS Negl. Trop. Dis. 2019, 13, e0007729. [Google Scholar] [CrossRef]
- Wisplinghoff, H. Pseudomonas Spp., Acinetobacter Spp. and Miscellaneous Gram-Negative Bacilli. In Infectious Diseases; Elsevier: Amsterdam, The Netherlands, 2017; pp. 1579–1599.e2. ISBN 978-0-7020-6285-8. [Google Scholar]
- Schoch, C.L.; Ciufo, S.; Domrachev, M.; Hotton, C.L.; Kannan, S.; Khovanskaya, R.; Leipe, D.; Mcveigh, R.; O’Neill, K.; Robbertse, B.; et al. NCBI Taxonomy: A Comprehensive Update on Curation, Resources and Tools. Database 2020, 2020, baaa062. [Google Scholar] [CrossRef]
- Finlay, B.B.; Falkow, S. Common Themes in Microbial Pathogenicity Revisited. Microbiol. Mol. Biol. Rev. 1997, 61, 136–169. [Google Scholar] [CrossRef]
- Park, W.S.; Lee, J.; Na, G.; Park, S.; Seo, S.-K.; Choi, J.S.; Jung, W.-K.; Choi, I.-W. Benzyl Isothiocyanate Attenuates Inflammasome Activation in Pseudomonas Aeruginosa LPS-Stimulated THP-1 Cells and Exerts Regulation through the MAPKs/NF-κB Pathway. Int. J. Mol. Sci. 2022, 23, 1228. [Google Scholar] [CrossRef]
- Geremia, N.; Giovagnorio, F.; Colpani, A.; De Vito, A.; Botan, A.; Stroffolini, G.; Toc, D.-A.; Zerbato, V.; Principe, L.; Madeddu, G.; et al. Fluoroquinolones and Biofilm: A Narrative Review. Pharmaceuticals 2024, 17, 1673. [Google Scholar] [CrossRef]
- LiPuma, J.; Currie, B.; Peacock, S.J.; Vandamme, P. Burkholderia, Stenotrophomonas, Ralstonia, Cupriavidus, Pandoraea, Brevundimonas, Comamonas, Delftia, and Acidovorax. In Manual of Clinical Microbiology; Jorgensen, J.H., Carroll, K.C., Funke, G., Pfaller, M.A., Eds.; American Society for Microbiology: Washington, DC, USA, 2015; Volume 1, pp. 791–812. ISBN 978-1-55581-737-4. [Google Scholar]
- Farfour, E.; Roux, A.; Sage, E.; Revillet, H.; Vasse, M.; Vallée, A. Rarely Encountered Gram-Negative Rods and Lung Transplant Recipients: A Narrative Review. Microorganisms 2023, 11, 1468. [Google Scholar] [CrossRef] [PubMed]
- Sfeir, M.M. Antimicrobial Susceptibility Testing for Glucose-Nonfermenting Gram-Negative Bacteria: The Tip of the Iceberg. Antimicrob. Agents Chemother. 2020, 64, e00011-20. [Google Scholar] [CrossRef]
- Eucast: EUCAST on “Intrinsic Resistance and Unusual Phenotypes” Updated. Available online: https://www.eucast.org/eucast_news/news_singleview?tx_ttnews%5Btt_news%5D=450&cHash=d75c16db85ee0d4369a4148e463d72a8 (accessed on 26 February 2025).
- Amoureux, L.; Bador, J.; Bounoua Zouak, F.; Chapuis, A.; de Curraize, C.; Neuwirth, C. Distribution of the Species of Achromobacter in a French Cystic Fibrosis Centre and Multilocus Sequence Typing Analysis Reveal the Predominance of A. Xylosoxidans and Clonal Relationships between Some Clinical and Environmental Isolates. J. Cyst. Fibros. 2016, 15, 486–494. [Google Scholar] [CrossRef]
- Coward, A.; Kenna, D.T.D.; Woodford, N.; Turton, J.F.; Members of the UK CF Surveillance Working Group. The UK CF Surveillance Working Group comprised Structured Surveillance of Achromobacter, Pandoraea and Ralstonia Species from Patients in England with Cystic Fibrosis. J. Cyst. Fibros. 2020, 19, 388–393. [Google Scholar] [CrossRef] [PubMed]
- Spilker, T.; Vandamme, P.; LiPuma, J.J. Identification and Distribution of Achromobacter Species in Cystic Fibrosis. J. Cyst. Fibros. 2013, 12, 298–301. [Google Scholar] [CrossRef]
- Neidhöfer, C.; Berens, C.; Parčina, M. An 18-Year Dataset on the Clinical Incidence and MICs to Antibiotics of Achromobacter Spp. (Labeled Biochemically or by MAL-DI-TOF MS as A. Xylosoxidans), Largely in Patient Groups Other than Those with CF. Antibiotics 2022, 11, 311. [Google Scholar] [CrossRef] [PubMed]
- Isler, B.; Kidd, T.J.; Stewart, A.G.; Harris, P.; Paterson, D.L. Achromobacter Infections and Treatment Options. Antimicrob. Agents Chemother. 2020, 64, e01025-20. [Google Scholar] [CrossRef]
- Papalia, M.; Figueroa-Espinosa, R.; Steffanowski, C.; Barberis, C.; Almuzara, M.; Barrios, R.; Vay, C.; Gutkind, G.; Di Conza, J.; Radice, M. Expansion and Improvement of MALDI-TOF MS Databases for Accurate Identification of Achromobacter Species. J. Microbiol. Methods 2020, 172, 105889. [Google Scholar] [CrossRef]
- Gómez-Cerezo, J.; Suárez, I.; Ríos, J.J.; Peña, P.; García de Miguel, M.J.; de José, M.; Monteagudo, O.; Linares, P.; Barbado-Cano, A.; Vázquez, J.J. Achromobacter Xylosoxidans Bacteremia: A 10-Year Analysis of 54 Cases. Eur. J. Clin. Microbiol. Infect. Dis. 2003, 22, 360–363. [Google Scholar] [CrossRef]
- Yoon, S.H.; Kim, H.; Lim, S.M.; Kang, J.-M. Nosocomial Outbreak of Achromobacter Spp. Bacteremia Due to Germicide Contamination: A Systematic Review. Eur. Rev. Med. Pharmacol. Sci. 2022, 26, 6374–6381. [Google Scholar] [CrossRef]
- Marion-Sanchez, K.; Pailla, K.; Olive, C.; Le Coutour, X.; Derancourt, C. Achromobacter Spp. Healthcare Associated Infections in the French West Indies: A Longitudinal Study from 2006 to 2016. BMC Infect Dis 2019, 19, 795. [Google Scholar] [CrossRef] [PubMed]
- Tena, D.; González-Praetorius, A.; Pérez-Balsalobre, M.; Sancho, O.; Bisquert, J. Urinary Tract Infection Due to Achromobacter Xylosoxidans: Report of 9 Cases. Scand. J. Infect. Dis. 2008, 40, 84–87. [Google Scholar] [CrossRef] [PubMed]
- Tena, D.; Martínez, N.M.; Losa, C.; Solís, S. Skin and Soft Tissue Infection Caused by Achromobacter Xylosoxidans: Report of 14 Cases. Scand. J. Infect. Dis. 2014, 46, 130–135. [Google Scholar] [CrossRef] [PubMed]
- Arshad, J.I.; Saud, A.; White, D.E.; Afshari, N.A.; Sayegh, R.R. Chronic Conjunctivitis From a Retained Contact Lens. Eye Contact Lens 2020, 46, e1–e4. [Google Scholar] [CrossRef]
- Xia, R.; Otto, C.; Zeng, J.; Momeni-Boroujeni, A.; Kagan, J.; Meleney, K.; Libien, J. Achromobacter Endocarditis in Native Cardiac Valves—An Autopsy Case Report and Review of the Literature. Cardiovasc. Pathol. 2018, 36, 6–10. [Google Scholar] [CrossRef]
- Veschetti, L.; Boaretti, M.; Saitta, G.M.; Passarelli Mantovani, R.; Lleò, M.M.; Sandri, A.; Malerba, G. Achromobacter Spp. Prevalence and Adaptation in Cystic Fibrosis Lung Infection. Microbiol. Res. 2022, 263, 127140. [Google Scholar] [CrossRef]
- Liu, C.; Pan, F.; Guo, J.; Yan, W.; Jin, Y.; Liu, C.; Qin, L.; Fang, X. Hospital Acquired Pneumonia Due to Achromobacter Spp. in a Geriatric Ward in China: Clinical Characteristic, Genome Variability, Biofilm Production, Antibiotic Resistance and Integron in Isolated Strains. Front. Microbiol. 2016, 7, 621. [Google Scholar] [CrossRef]
- Olbrecht, M.; Echahidi, F.; Piérard, D.; Peeters, C.; Vandamme, P.; Wybo, I.; Demuyser, T. In Vitro Susceptibility of Achromobacter Species Isolated from Cystic Fibrosis Patients: A 6-Year Survey. Antimicrob. Agents Chemother. 2023, 67, e00379-23. [Google Scholar] [CrossRef] [PubMed]
- Bador, J.; Amoureux, L.; Blanc, E.; Neuwirth, C. Innate Aminoglycoside Resistance of Achromobacter Xylosoxidans Is Due to AxyXY-OprZ, an RND-Type Multidrug Efflux Pump. Antimicrob. Agents Chemother. 2013, 57, 603–605. [Google Scholar] [CrossRef]
- Yamamoto, M.; Nagao, M.; Hotta, G.; Matsumura, Y.; Matsushima, A.; Ito, Y.; Takakura, S.; Ichiyama, S. Molecular Characterization of IMP-Type Metallo-β-Lactamases among Multidrug-Resistant Achromobacter Xylosoxidans. J. Antimicrob. Chemother. 2012, 67, 2110–2113. [Google Scholar] [CrossRef]
- El Salabi, A.; Borra, P.S.; Toleman, M.A.; Samuelsen, Ø.; Walsh, T.R. Genetic and Biochemical Characterization of a Novel Metallo-β-Lactamase, TMB-1, from an Achromobacter Xylosoxidans Strain Isolated in Tripoli, Libya. Antimicrob. Agents Chemother. 2012, 56, 2241–2245. [Google Scholar] [CrossRef]
- Eucast: Clinical Breakpoints and Dosing of Antibiotics. Available online: https://www.eucast.org/clinical_breakpoints (accessed on 22 May 2024).
- CLSI eClipse Ultimate Access—Powered by Edaptive Technologies. Available online: https://em100.edaptivedocs.net/Login.aspx?_ga=2.174075298.1086753664.1709112633-1991978545.1705003341 (accessed on 2 February 2025).
- Beauruelle, C.; Lamoureux, C.; Mashi, A.; Ramel, S.; Le Bihan, J.; Ropars, T.; Dirou, A.; Banerjee, A.; Tandé, D.; Le Bars, H.; et al. In Vitro Activity of 22 Antibiotics against Achromobacter Isolates from People with Cystic Fibrosis. Are There New Therapeutic Options? Microorganisms 2021, 9, 2473. [Google Scholar] [CrossRef]
- Denton, M.; Kerr, K.G. Microbiological and Clinical Aspects of Infection Associated with Stenotrophomonas Maltophilia. Clin. Microbiol. Rev. 1998, 11, 57–80. [Google Scholar] [CrossRef]
- Huang, C. Extensively Drug-Resistant Alcaligenes Faecalis Infection. BMC Infect. Dis. 2020, 20, 833. [Google Scholar] [CrossRef] [PubMed]
- Zorina, A.S.; Maksimova, Y.G.; Demakov, V.A. Biofilm Formation by Monocultures and Mixed Cultures of Alcaligenes Faecalis 2 and Rhodococcus Ruber Gt 1. Microbiology 2019, 88, 164–171. [Google Scholar] [CrossRef]
- Spernovasilis, N.; Ierodiakonou, D.; Milioni, A.; Markaki, L.; Kofteridis, D.P.; Tsioutis, C. Assessing the Knowledge, Attitudes and Perceptions of Junior Doctors on Antimicrobial Use and Antimicrobial Resistance in Greece. J. Glob. Antimicrob. Resist. 2020, 21, 296–302. [Google Scholar] [CrossRef] [PubMed]
- Mishra, A.; Aggarwal, A.; Khan, F. Medical Device-Associated Infections Caused by Biofilm-Forming Microbial Pathogens and Controlling Strategies. Antibiotics 2024, 13, 623. [Google Scholar] [CrossRef]
- Marino, A.; Pulvirenti, S.; Campanella, E.; Stracquadanio, S.; Ceccarelli, M.; Micali, C.; Tina, L.G.; Di Dio, G.; Stefani, S.; Cacopardo, B.; et al. Ceftazidime-Avibactam Treatment for Klebsiella Pneumoniae Bacteremia in Preterm Infants in NICU: A Clinical Experience. Antibiotics 2023, 12, 1169. [Google Scholar] [CrossRef]
- Marino, A.; Campanella, E.; Stracquadanio, S.; Calvo, M.; Migliorisi, G.; Nicolosi, A.; Cosentino, F.; Marletta, S.; Spampinato, S.; Prestifilippo, P.; et al. Ceftazidime/Avibactam and Meropenem/Vaborbactam for the Management of Enterobacterales Infections: A Narrative Review, Clinical Considerations, and Expert Opinion. Antibiotics 2023, 12, 1521. [Google Scholar] [CrossRef]
- Devanga Ragupathi, N.K.; Veeraraghavan, B. Accurate Identification and Epidemiological Characterization of Burkholderia Cepacia Complex: An Update. Ann. Clin. Microbiol. Antimicrob. 2019, 18, 7. [Google Scholar] [CrossRef]
- Yabuuchi, E.; Kosako, Y.; Oyaizu, H.; Yano, I.; Hotta, H.; Hashimoto, Y.; Ezaki, T.; Arakawa, M. Proposal of Burkholderia Gen. Nov. and Transfer of Seven Species of the Genus Pseudomonas Homology Group II to the New Genus, with the Type Species Burkholderia Cepacia (Palleroni and Holmes 1981) Comb. Nov. Microbiol. Immunol. 1992, 36, 1251–1275. [Google Scholar] [CrossRef]
- Rhodes, K.A.; Schweizer, H.P. Antibiotic Resistance in Burkholderia Species. Drug Resist. Updat. 2016, 28, 82–90. [Google Scholar] [CrossRef] [PubMed]
- Kalish, L.A.; Waltz, D.A.; Dovey, M.; Potter-Bynoe, G.; McAdam, A.J.; LiPuma, J.J.; Gerard, C.; Goldmann, D. Impact of Burkholderia Dolosa on Lung Function and Survival in Cystic Fibrosis. Am. J. Respir. Crit. Care Med. 2006, 173, 421–425. [Google Scholar] [CrossRef]
- Zahariadis, G.; Levy, M.H.; Burns, J.L. Cepacia-Like Syndrome Caused by Burkholderia Mutivorans. Can. J. Infect. Dis. Med. Microbiol. 2003, 14, 675159. [Google Scholar] [CrossRef] [PubMed]
- Behroozian, S.; Zlosnik, J.E.A.; Xu, W.; Li, L.Y.; Davies, J.E. Antibacterial Activity of a Natural Clay Mineral against Burkholderia Cepacia Complex and Other Bacterial Pathogens Isolated from People with Cystic Fibrosis. Microorganisms 2023, 11, 150. [Google Scholar] [CrossRef] [PubMed]
- Blanchard, A.C.; Waters, V.J. Microbiology of Cystic Fibrosis Airway Disease. Semin. Respir. Crit. Care Med. 2019, 40, 727–736. [Google Scholar] [CrossRef]
- Nye, C.; Duckers, J.; Dhillon, R. Cefiderocol to Manage Chronic, Multi-Drug-Resistant Burkholderia Cepacia Complex Infection in a Patient with Cystic Fibrosis: A Case Report. Access Microbiol. 2022, 4, 000413. [Google Scholar] [CrossRef]
- Akkerman-Nijland, A.M.; Rottier, B.L.; Holstein, J.; Winter, R.L.J.; Touw, D.J.; Akkerman, O.W.; Koppelman, G.H. Eradication of Burkholderia Cepacia Complex in Cystic Fibrosis Patients with Inhalation of Amiloride and Tobramycin Combined with Oral Cotrimoxazole. ERJ Open Res. 2023, 9, 00055–02023. [Google Scholar] [CrossRef]
- Len, O.; Los-Arcos, I.; Aguado, J.M.; Blanes, M.; Bodro, M.; Carratalà, J.; Cordero, E.; Fariñas, M.C.; Fernández-Ruiz, M.; Fortún, J.; et al. Selection Criteria of Solid Organ Donors in Relation to Infectious Diseases: A Spanish Consensus. Transplant. Rev. 2020, 34, 100528. [Google Scholar] [CrossRef]
- Mahenthiralingam, E.; Vandamme, P. Taxonomy and Pathogenesis of the Burkholderia Cepacia Complex. Chron. Respir. Dis. 2005, 2, 209–217. [Google Scholar] [CrossRef]
- Isles, A.; Maclusky, I.; Corey, M.; Gold, R.; Prober, C.; Fleming, P.; Levison, H. Pseudomonas Cepacia Infection in Cystic Fibrosis: An Emerging Problem. J. Pediatr. 1984, 104, 206–210. [Google Scholar] [CrossRef]
- Sfeir, M.M. Burkholderia Cepacia Complex Infections: More Complex than the Bacterium Name Suggest. J. Infect. 2018, 77, 166–170. [Google Scholar] [CrossRef] [PubMed]
- Gutiérrez Santana, J.C.; Coria Jiménez, V.R. Burkholderia Cepacia Complex in Cystic Fibrosis: Critical Gaps in Diagnosis and Therapy. Ann. Med. 2024, 56, 2307503. [Google Scholar] [CrossRef]
- Mahenthiralingam, E.; Campbell, M.; Speert, D.P. Burkholderia Cepacia in Cystic Fibrosis. N. Engl. J. Med. 1995, 332, 819. [Google Scholar] [CrossRef]
- Tseng, S.-P.; Tsai, W.-C.; Liang, C.-Y.; Lin, Y.-S.; Huang, J.-W.; Chang, C.-Y.; Tyan, Y.-C.; Lu, P.-L. The Contribution of Antibiotic Resistance Mechanisms in Clinical Burkholderia Cepacia Complex Isolates: An Emphasis on Efflux Pump Activity. PLoS ONE 2014, 9, e104986. [Google Scholar] [CrossRef]
- Abbott, F.K.; Milne, K.E.N.; Stead, D.A.; Gould, I.M. Combination Antimicrobial Susceptibility Testing of Burkholderia Cepacia Complex: Significance of Species. Int. J. Antimicrob. Agents 2016, 48, 521–527. [Google Scholar] [CrossRef] [PubMed]
- Papp-Wallace, K.M.; Becka, S.A.; Zeiser, E.T.; Ohuchi, N.; Mojica, M.F.; Gatta, J.A.; Falleni, M.; Tosi, D.; Borghi, E.; Winkler, M.L.; et al. Overcoming an Extremely Drug Resistant (XDR) Pathogen: Avibactam Restores Susceptibility to Ceftazidime for Burkholderia Cepacia Complex Isolates from Cystic Fibrosis Patients. ACS Infect. Dis. 2017, 3, 502–511. [Google Scholar] [CrossRef] [PubMed]
- Sutcliffe, J.A.; O’Brien, W.; Fyfe, C.; Grossman, T.H. Antibacterial Activity of Eravacycline (TP-434), a Novel Fluorocycline, against Hospital and Community Pathogens. Antimicrob. Agents Chemother. 2013, 57, 5548–5558. [Google Scholar] [CrossRef]
- Van Dalem, A.; Herpol, M.; Echahidi, F.; Peeters, C.; Wybo, I.; De Wachter, E.; Vandamme, P.; Piérard, D. In Vitro Susceptibility of Burkholderia Cepacia Complex Isolated from Cystic Fibrosis Patients to Ceftazidime-Avibactam and Ceftolozane-Tazobactam. Antimicrob. Agents Chemother. 2018, 62, e00590-18. [Google Scholar] [CrossRef] [PubMed]
- Shi, H.; Chen, X.; Chen, L.; Zhu, B.; Yan, W.; Ma, X. Burkholderia Cepacia Infection in Children without Cystic Fibrosis: A Clinical Analysis of 50 Cases. Front. Pediatr. 2023, 11, 1115877. [Google Scholar] [CrossRef]
- Yamano, Y. In Vitro Activity of Cefiderocol Against a Broad Range of Clinically Important Gram-Negative Bacteria. Clin. Infect. Dis. 2019, 69, S544–S551. [Google Scholar] [CrossRef]
- Rolston, K.V.I.; Gerges, B.; Shelburne, S.; Aitken, S.L.; Raad, I.; Prince, R.A. Activity of Cefiderocol and Comparators against Isolates from Cancer Patients. Antimicrob. Agents Chemother. 2020, 64, 10–1128. [Google Scholar] [CrossRef]
- Farfour, E.; d’Epenoux, L.R.; Muggeo, A.; Alauzet, C.; Crémet, L.; Moussalih, S.; Roux, A.; de Verdière, S.C.; Bosphore, A.; Corvec, S.; et al. In Vitro Susceptibility of Nonfermenting Gram-Negative Rods To Meropenem–Vaborbactam and Delafloxacin. Future Microbiol. 2023, 18, 117–126. [Google Scholar] [CrossRef]
- McCarthy, B.; Casey, D.; Devane, D.; Murphy, K.; Murphy, E.; Lacasse, Y. Pulmonary Rehabilitation for Chronic Obstructive Pulmonary Disease. Cochrane Database Syst. Rev. 2015, 2015, CD003793. [Google Scholar] [CrossRef]
- Burton, J.K.; Craig, L.E.; Yong, S.Q.; Siddiqi, N.; Teale, E.A.; Woodhouse, R.; Barugh, A.J.; Shepherd, A.M.; Brunton, A.; Freeman, S.C.; et al. Non-Pharmacological Interventions for Preventing Delirium in Hospitalised Non-ICU Patients. Cochrane Database Syst. Rev. 2021, 7, CD013307. [Google Scholar] [CrossRef]
- Haidar, G.; Chan, B.K.; Cho, S.-T.; Hughes Kramer, K.; Nordstrom, H.R.; Wallace, N.R.; Stellfox, M.E.; Holland, M.; Kline, E.G.; Kozar, J.M.; et al. Phage Therapy in a Lung Transplant Recipient with Cystic Fibrosis Infected with Multidrug-Resistant Burkholderia Multivorans. Transpl. Infect. Dis. 2023, 25, e14041. [Google Scholar] [CrossRef]
- Narayanaswamy, V.P.; Giatpaiboon, S.; Baker, S.M.; Wiesmann, W.P.; LiPuma, J.J.; Townsend, S.M. Novel Glycopolymer Sensitizes Burkholderia Cepacia Complex Isolates from Cystic Fibrosis Patients to Tobramycin and Meropenem. PLoS ONE 2017, 12, e0179776. [Google Scholar] [CrossRef]
- Maydaniuk, D.; Wu, B.; Truong, D.; Liyanage, S.H.; Hogan, A.M.; Yap, Z.L.; Yan, M.; Cardona, S.T. New Auranofin Analogs with Antibacterial Properties against Burkholderia Clinical Isolates. Antibiotics 2021, 10, 1443. [Google Scholar] [CrossRef]
- Peacock, S.J.; Schweizer, H.P.; Dance, D.A.B.; Smith, T.L.; Gee, J.E.; Wuthiekanun, V.; DeShazer, D.; Steinmetz, I.; Tan, P.; Currie, B.J. Management of Accidental Laboratory Exposure to Burkholderia Pseudomallei and B. Mallei. Emerg. Infect. Dis. J. 2008, 14, e2. [Google Scholar] [CrossRef]
- Cheng, A.C.; Dance, D.a.B.; Currie, B.J. Bioterrorism, Glanders and Melioidosis. Eurosurveillance 2005, 10, 11–12. [Google Scholar] [CrossRef]
- Schmoock, G.; Elschner, M.; Sprague, L.D. Clear Distinction between Burkholderia Mallei and Burkholderia Pseudomallei Using Fluorescent motB Primers. Acta Vet. Scand. 2015, 57, 13. [Google Scholar] [CrossRef]
- Gassiep, I.; Armstrong, M.; Norton, R. Human Melioidosis. Clin. Microbiol. Rev. 2020, 33, e00006-19. [Google Scholar] [CrossRef]
- Chakravorty, A.; Heath, C. Melioidosis: An Updated Review. Aust. J. Gen. Pract. 2019, 48, 327–332. [Google Scholar] [CrossRef]
- Wiersinga, W.J.; Currie, B.J.; Peacock, S.J. Melioidosis. N. Engl. J. Med. 2012, 367, 1035–1044. [Google Scholar] [CrossRef]
- Cheng, A.C.; Currie, B.J. Melioidosis: Epidemiology, Pathophysiology, and Management. Clin. Microbiol. Rev. 2005, 18, 383–416. [Google Scholar] [CrossRef]
- Wiersinga, W.J.; Virk, H.S.; Torres, A.G.; Currie, B.J.; Peacock, S.J.; Dance, D.A.B.; Limmathurotsakul, D. Melioidosis. Nat. Rev. Dis. Primers 2018, 4, 1–22. [Google Scholar] [CrossRef]
- Karunanayake, P. Melioidosis: Clinical Aspects. Clin. Med. 2022, 22, 6–8. [Google Scholar] [CrossRef]
- Hatcher, C.L.; Muruato, L.A.; Torres, A.G. Recent Advances in Burkholderia Mallei and B. Pseudomallei Research. Curr. Trop. Med. Rep. 2015, 2, 62–69. [Google Scholar] [CrossRef]
- Dance, D.A.B.; Wuthiekanun, V.; Chaowagul, W.; White, N.J. The Antimicrobial Susceptibility of Pseudomonas Pseudomallei. Emergence of Resistance in Vitro and during Treatment. J. Antimicrob. Chemother. 1989, 24, 295–309. [Google Scholar] [CrossRef]
- Jenney, A.W.J.; Lum, G.; Fisher, D.A.; Currie, B.J. Antibiotic Susceptibility of Burkholderia Pseudomallei from Tropical Northern Australia and Implications for Therapy of Melioidosis. Int. J. Antimicrob. Agents 2001, 17, 109–113. [Google Scholar] [CrossRef]
- Currie, B.J. Melioidosis: Evolving Concepts in Epidemiology, Pathogenesis, and Treatment. Semin. Respir. Crit. Care Med. 2015, 36, 111–125. [Google Scholar] [CrossRef]
- Lipsitz, R.; Garges, S.; Aurigemma, R.; Baccam, P.; Blaney, D.D.; Cheng, A.C.; Currie, B.J.; Dance, D.; Gee, J.E.; Larsen, J.; et al. Workshop on Treatment of and Postexposure Prophylaxis for Burkholderia Pseudomallei and B. Mallei Infection, 2010. Emerg. Infect. Dis. 2012, 18, e2. [Google Scholar] [CrossRef]
- Pitman, M.C.; Luck, T.; Marshall, C.S.; Anstey, N.M.; Ward, L.; Currie, B.J. Intravenous Therapy Duration and Outcomes in Melioidosis: A New Treatment Paradigm. PLoS Neglected Trop. Dis. 2015, 9, e0003586. [Google Scholar] [CrossRef]
- Van Zandt, K.E.; Greer, M.T.; Gelhaus, H.C. Glanders: An Overview of Infection in Humans. Orphanet J. Rare Dis. 2013, 8, 131. [Google Scholar] [CrossRef]
- Dvorak, G.D.; Spickler, A.R. Glanders. J. Am. Vet. Med. Assoc. 2008, 233, 570–577. [Google Scholar] [CrossRef]
- Burnard, D.; Robertson, G.; Henderson, A.; Falconer, C.; Bauer, M.J.; Cottrell, K.; Gassiep, I.; Norton, R.; Paterson, D.L.; Harris, P.N.A. Burkholderia Pseudomallei Clinical Isolates Are Highly Susceptible In Vitro to Cefiderocol, a Siderophore Cephalosporin. Antimicrob. Agents Chemother. 2021, 65, 10.–1128. [Google Scholar] [CrossRef]
- Tapia, D.; Sanchez-Villamil, J.I.; Torres, A.G. Emerging Role of Biologics for the Treatment of Melioidosis and Glanders. Expert. Opin. Biol. Ther. 2019, 19, 1319–1332. [Google Scholar] [CrossRef]
- Eickhoff, T.C.; Bennett, J.V.; Hayes, P.S.; Feeley, J. Pseudomonas Pseudomallei: Susceptibility to Chemotherapeutic Agents. J. Infect. Dis. 1970, 121, 95–102. [Google Scholar] [CrossRef]
- Chan, Y.Y.; Tan, T.M.C.; Ong, Y.M.; Chua, K.L. BpeAB-OprB, a Multidrug Efflux Pump in Burkholderia Pseudomallei. Antimicrob. Agents Chemother. 2004, 48, 1128–1135. [Google Scholar] [CrossRef]
- Moore, R.A.; DeShazer, D.; Reckseidler, S.; Weissman, A.; Woods, D.E. Efflux-Mediated Aminoglycoside and Macrolide Resistance in Burkholderia Pseudomallei. Antimicrob. Agents Chemother. 1999, 43, 465–470. [Google Scholar] [CrossRef]
- Anuntagool, N.; Wuthiekanun, V.; White, N.J.; Currie, B.J.; Sermswan, R.W.; Wongratanacheewin, S.; Taweechaisupapong, S.; Chaiyaroj, S.C.; Sirisinha, S. LIPOPOLYSACCHARIDE HETEROGENEITY AMONG BURKHOLDERIA PSEUDOMALLEI FROM DIFFERENT GEOGRAPHIC AND CLINICAL ORIGINS. Am. J. Trop. Med. Hyg. 2006, 74, 348–352. [Google Scholar] [CrossRef]
- Sawasdidoln, C.; Taweechaisupapong, S.; Sermswan, R.W.; Tattawasart, U.; Tungpradabkul, S.; Wongratanacheewin, S. Growing Burkholderia Pseudomallei in Biofilm Stimulating Conditions Significantly Induces Antimicrobial Resistance. PLoS ONE 2010, 5, e9196. [Google Scholar] [CrossRef] [PubMed]
- Zemanick, E.T.; Hoffman, L.R. Cystic Fibrosis: Microbiology and Host Response. Pediatr. Clin. N. Am. 2016, 63, 617–636. [Google Scholar] [CrossRef]
- Gruzelle, V.; Guet-Revillet, H.; Segonds, C.; Bui, S.; Macey, J.; Chiron, R.; Michelet, M.; Murris-Espin, M.; Mittaine, M. Management of Initial Colonisations with Burkholderia Species in France, with Retrospective Analysis in Five Cystic Fibrosis Centres: A Pilot Study. BMC Pulm. Med. 2020, 20, 159. [Google Scholar] [CrossRef]
- King, E.O. Studies on a Group of Previously Unclassified Bacteria Associated with Meningitis in Infants. Am. J. Clin. Pathol. 1959, 31, 241–247. [Google Scholar] [CrossRef]
- Lin, J.-N.; Lai, C.-H.; Yang, C.-H.; Huang, Y.-H. Elizabethkingia Infections in Humans: From Genomics to Clinics. Microorganisms 2019, 7, 295. [Google Scholar] [CrossRef]
- Dziuban, E.J.; Franks, J.L.; So, M.; Peacock, G.; Blaney, D.D. Elizabethkingia in Children: A Comprehensive Review of Symptomatic Cases Reported From 1944 to 2017. Clin. Infect. Dis. 2018, 67, 144–149. [Google Scholar] [CrossRef]
- Zajmi, A.; Teo, J.; Yeo, C.C. Epidemiology and Characteristics of Elizabethkingia Spp. Infections in Southeast Asia. Microorganisms 2022, 10, 882. [Google Scholar] [CrossRef]
- Kämpfer, P.; Matthews, H.; Glaeser, S.P.; Martin, K.; Lodders, N.; Faye, I. Elizabethkingia Anophelis Sp. Nov., Isolated from the Midgut of the Mosquito Anopheles Gambiae. Int. J. Syst. Evol. Microbiol. 2011, 61, 2670–2675. [Google Scholar] [CrossRef] [PubMed]
- Hem, S.; Jarocki, V.M.; Baker, D.J.; Charles, I.G.; Drigo, B.; Aucote, S.; Donner, E.; Burnard, D.; Bauer, M.J.; Harris, P.N.A.; et al. Genomic Analysis of Elizabethkingia Species from Aquatic Environments: Evidence for Potential Clinical Transmission. Curr. Res. Microb. Sci. 2021, 3, 100083. [Google Scholar] [CrossRef] [PubMed]
- Hwang, J.-H.; Kim, J.; Kim, J.; Mo, S. Elizabethkingia Argenteiflava Sp. Nov., Isolated from the Pod of Soybean, Glycine Max. Int. J. Syst. Evol. Microbiol. 2021, 71, 004767. [Google Scholar] [CrossRef] [PubMed]
- Perrin, A.; Larsonneur, E.; Nicholson, A.C.; Edwards, D.J.; Gundlach, K.M.; Whitney, A.M.; Gulvik, C.A.; Bell, M.E.; Rendueles, O.; Cury, J.; et al. Evolutionary Dynamics and Genomic Features of the Elizabethkingia Anophelis 2015 to 2016 Wisconsin Outbreak Strain. Nat Commun 2017, 8, 15483. [Google Scholar] [CrossRef] [PubMed]
- Guerpillon, B.; Fangous, M.S.; Le Breton, E.; Artus, M.; le Gall, F.; Khatchatourian, L.; Talarmin, J.P.; Plesiat, P.; Jeannot, K.; Saidani, N.; et al. Elizabethkingia Anophelis Outbreak in France. Infect. Dis. Now. 2022, 52, 299–303. [Google Scholar] [CrossRef]
- Lau, S.K.P.; Chow, W.-N.; Foo, C.-H.; Curreem, S.O.T.; Lo, G.C.-S.; Teng, J.L.L.; Chen, J.H.K.; Ng, R.H.Y.; Wu, A.K.L.; Cheung, I.Y.Y.; et al. Elizabethkingia Anophelis Bacteremia Is Associated with Clinically Significant Infections and High Mortality. Sci. Rep. 2016, 6, 26045. [Google Scholar] [CrossRef]
- Hoque, S.N.; Graham, J.; Kaufmann, M.E.; Tabaqchali, S. Chryseobacterium (Flavobacterium) Meningosepticum Outbreak Associated with Colonization of Water Taps in a Neonatal Intensive Care Unit. J. Hosp. Infect. 2001, 47, 188–192. [Google Scholar] [CrossRef]
- Comba, I.Y.; Schuetz, A.N.; Misra, A.; Friedman, D.Z.P.; Stevens, R.; Patel, R.; Lancaster, Z.D.; Shah, A. Antimicrobial Susceptibility of Elizabethkingia Species: Report from a Reference Laboratory. J. Clin. Microbiol. 2022, 60, e02541-21. [Google Scholar] [CrossRef]
- Wu, C.; Xiong, L.; Liao, Q.; Zhang, W.; Xiao, Y.; Xie, Y. Clinical Manifestations, Antimicrobial Resistance and Genomic Feature Analysis of Multidrug-Resistant Elizabethkingia Strains. Ann. Clin. Microbiol. Antimicrob. 2024, 23, 32. [Google Scholar] [CrossRef] [PubMed]
- Hu, S.; Lv, Y.; Xu, H.; Zheng, B.; Xiao, Y. Biofilm Formation and Antibiotic Sensitivity in Elizabethkingia Anophelis. Front. Cell. Infect. Microbiol. 2022, 12, 953780. [Google Scholar] [CrossRef]
- Huang, Y.-S.; Chuang, Y.-C.; Chen, P.-Y.; Chou, P.-C.; Wang, J.-T. In Vitro Activity of Cefiderocol and Comparator Antibiotics against Multidrug-Resistant Non-Fermenting Gram-Negative Bacilli. JAC Antimicrob. Resist. 2024, 6, dlae006. [Google Scholar] [CrossRef]
- Puah, S.M.; Fong, S.P.; Kee, B.P.; Puthucheary, S.D.; Chua, K.H. Molecular Identification and Biofilm-Forming Ability of Elizabethkingia Species. Microb. Pathog. 2022, 162, 105345. [Google Scholar] [CrossRef]
- Verduin, C.M.; Hol, C.; Fleer, A.; van Dijk, H.; van Belkum, A. Moraxella Catarrhalis: From Emerging to Established Pathogen. Clin. Microbiol. Rev. 2002, 15, 125–144. [Google Scholar] [CrossRef] [PubMed]
- Ho, K.-T.; Su, K.-W.; Liao, S.-L.; Chiu, C.-Y.; Hua, M.-C.; Huang, J.-L.; Huang, Y.-C.; Chiu, C.-H.; Lin, T.-Y.; Tsai, M.-H. Longitudinal Investigation of Pathogenic Bacterial Colonization in Early Childhood: Emphasis on the Determinants of Moraxella Catarrhalis Colonization. J. Microbiol. Immunol. Infect. 2023, 56, 373–381. [Google Scholar] [CrossRef] [PubMed]
- Verhaegh, S.J.C.; Snippe, M.L.; Levy, F.; Verbrugh, H.A.; Jaddoe, V.W.V.; Hofman, A.; Moll, H.A.; van Belkum, A.; Hays, J.P. Colonization of Healthy Children by Moraxella Catarrhalis Is Characterized by Genotype Heterogeneity, Virulence Gene Diversity and Co-Colonization with Haemophilus Influenzae. Microbiology 2011, 157, 169–178. [Google Scholar] [CrossRef]
- Sillanpää, S.; Oikarinen, S.; Sipilä, M.; Kramna, L.; Rautiainen, M.; Huhtala, H.; Aittoniemi, J.; Laranne, J.; Hyöty, H.; Cinek, O. Moraxella Catarrhalis Might Be More Common than Expected in Acute Otitis Media in Young Finnish Children. J. Clin. Microbiol. 2016, 54, 2373–2379. [Google Scholar] [CrossRef] [PubMed]
- Fox-Lewis, A.; Coltart, G.; Rice, S.; Sen, R.; Gourtsoyannis, Y.; Hyare, H.; Gupta, R.K. Extensive Subclinical Sinusitis Leading to Moraxella Osloensis Meningitis. IDCases 2016, 6, 39–42. [Google Scholar] [CrossRef] [PubMed]
- Murphy, T.F.; Brauer, A.L.; Grant, B.J.B.; Sethi, S. Moraxella Catarrhalis in Chronic Obstructive Pulmonary Disease. Am. J. Respir. Crit. Care Med. 2005, 172, 195–199. [Google Scholar] [CrossRef]
- Karalus, R.; Campagnari, A. Moraxella Catarrhalis: A Review of an Important Human Mucosal Pathogen. Microbes Infect. 2000, 2, 547–559. [Google Scholar] [CrossRef]
- Koleri, J.; Petkar, H.M.; Husain, A.A.M.; Almaslamani, M.A.; Omrani, A.S. Moraxella Osloensis Bacteremia, a Case Series and Review of the Literature. IDCases 2022, 27, e01450. [Google Scholar] [CrossRef]
- Sawada, N.; Morohashi, T.; Mutoh, T.; Kuwana, T.; Yamaguchi, J.; Kinoshita, K.; Morioka, I.; Hao, H. Moraxella Lacunata Infection Accompanied by Acute Glomerulonephritis. Open Med. 2020, 15, 962–967. [Google Scholar] [CrossRef]
- Zaman, S.; Greene, J. Moraxella Bacteremia in Cancer Patients. Cureus 2021, 13, e15316. [Google Scholar] [CrossRef]
- Correa-Martínez, C.L.; Rauwolf, K.K.; Schuler, F.; Füller, M.; Kampmeier, S.; Groll, A.H. Moraxella Nonliquefaciens Bloodstream Infection and Sepsis in a Pediatric Cancer Patient: Case Report and Literature Review. BMC Infect. Dis. 2019, 19, 836. [Google Scholar] [CrossRef] [PubMed]
- Postma, G.C.; Carfagnini, J.C.; Minatel, L. Moraxella Bovis Pathogenicity: An Update. Comp. Immunol. Microbiol. Infect. Dis. 2008, 31, 449–458. [Google Scholar] [CrossRef] [PubMed]
- Hoban, D.J.; Doern, G.V.; Fluit, A.C.; Roussel-Delvallez, M.; Jones, R.N. Worldwide Prevalence of Antimicrobial Resistance in Streptococcus Pneumoniae, Haemophilus Influenzae, and Moraxella Catarrhalis in the SENTRY Antimicrobial Surveillance Program, 1997–1999. Clin. Infect. Dis. 2001, 32, S81–S93. [Google Scholar] [CrossRef]
- Mulu, W.; Yizengaw, E.; Alemu, M.; Mekonnen, D.; Hailu, D.; Ketemaw, K.; Abera, B.; Kibret, M. Pharyngeal Colonization and Drug Resistance Profiles of Morraxella Catarrrhalis, Streptococcus Pneumoniae, Staphylococcus Aureus, and Haemophilus Influenzae among HIV Infected Children Attending ART Clinic of Felegehiwot Referral Hospital, Ethiopia. PLoS ONE 2018, 13, e0196722. [Google Scholar] [CrossRef]
- Beekmann, S.E.; Heilmann, K.P.; Richter, S.S.; García-de-Lomas, J.; Doern, G.V. Antimicrobial Resistance in Streptococcus Pneumoniae, Haemophilus Influenzae, Moraxella Catarrhalis and Group A β-Haemolytic Streptococci in 2002–2003. Int. J. Antimicrob. Agents 2005, 25, 148–156. [Google Scholar] [CrossRef]
- Esel, D.; Ay-Altintop, Y.; Yagmur, G.; Gokahmetoglu, S.; Sumerkan, B. Evaluation of Susceptibility Patterns and BRO β-Lactamase Types among Clinical Isolates of Moraxella Catarrhalis. Clin. Microbiol. Infect. 2007, 13, 1023–1025. [Google Scholar] [CrossRef] [PubMed]
- Kaderabkova, N.; Bharathwaj, M.; Furniss, R.C.D.; Gonzalez, D.; Palmer, T.; Mavridou, D.A.I. The Biogenesis of β-Lactamase Enzymes. Microbiology 2022, 168, 001217. [Google Scholar] [CrossRef]
- Raveendran, S.; Kumar, G.; Sivanandan, R.N.; Dias, M. Moraxella Catarrhalis: A Cause of Concern with Emerging Resistance and Presence of BRO Beta-Lactamase Gene—Report from a Tertiary Care Hospital in South India. Int. J. Microbiol. 2020, 2020, 7316257. [Google Scholar] [CrossRef]
- Powell, M.; McVey, D.; Kassim, M.H.; Chen, H.Y.; Williams, J.D. Antimicrobial Susceptibility of Streptococcus Pneumoniae, Haemophilus Influenzae and Moraxella (Branhamella) Catarrhalis Isolated in the UK from Sputa. J. Antimicrob. Chemother. 1991, 28, 249–259. [Google Scholar] [CrossRef]
- Bair, K.L.; Campagnari, A.A. Moraxella Catarrhalis Promotes Stable Polymicrobial Biofilms With the Major Otopathogens. Front. Microbiol. 2019, 10, 3006. [Google Scholar] [CrossRef]
- Armbruster, C.E.; Hong, W.; Pang, B.; Weimer, K.E.D.; Juneau, R.A.; Turner, J.; Swords, W.E. Indirect Pathogenicity of Haemophilus Influenzae and Moraxella Catarrhalis in Polymicrobial Otitis Media Occurs via Interspecies Quorum Signaling. mBio 2010, 1, e00102-10. [Google Scholar] [CrossRef]
- Flamm, R.K.; Sader, H.S.; Farrell, D.J.; Jones, R.N. Macrolide and Tetracycline Resistance among Moraxella Catarrhalis Isolates from 2009 to 2011. Diagn. Microbiol. Infect. Dis. 2012, 74, 198–200. [Google Scholar] [CrossRef]
- Hsu, S.-F.; Lin, Y.-T.; Chen, T.-L.; Siu, L.K.; Hsueh, P.-R.; Huang, S.-T.; Fung, C.-P. Antimicrobial Resistance of Moraxella Catarrhalis Isolates in Taiwan. J. Microbiol. Immunol. Infect. 2012, 45, 134–140. [Google Scholar] [CrossRef] [PubMed]
- Wallace, R.J., Jr.; Nash, D.R.; Steingrube, V.A. Antibiotic Susceptibilities and Drug Resistance in Moraxella (Branhamella) Catarrhalis. Am. J. Med. 1990, 88, S46–S50. [Google Scholar] [CrossRef] [PubMed]
- Roberts, M.C.; Pang, Y.J.; Spencer, R.C.; Winstanley, T.G.; Brown, B.A.; Wallace, R.J. Tetracycline Resistance in Moraxella (Branhamella) Catarrhalis: Demonstration of Two Clonal Outbreaks by Using Pulsed-Field Gel Electrophoresis. Antimicrob. Agents Chemother. 1991, 35, 2453–2455. [Google Scholar] [CrossRef]
- Moreno, E.; Middlebrook, E.A.; Altamirano-Silva, P.; Al Dahouk, S.; Araj, G.F.; Arce-Gorvel, V.; Arenas-Gamboa, Á.; Ariza, J.; Barquero-Calvo, E.; Battelli, G.; et al. If You’re Not Confused, You’re Not Paying Attention: Ochrobactrum Is Not Brucella. J. Clin. Microbiol. 2023, 61, e00438-23. [Google Scholar] [CrossRef] [PubMed]
- Kettaneh, A.; Weill, F.-X.; Poilane, I.; Fain, O.; Thomas, M.; Herrmann, J.-L.; Hocqueloux, L. Septic Shock Caused by Ochrobactrum Anthropi in an Otherwise Healthy Host. J. Clin. Microbiol. 2003, 41, 1339–1341. [Google Scholar] [CrossRef]
- Ryan, M.P.; Pembroke, J.T. The Genus Ochrobactrum as Major Opportunistic Pathogens. Microorganisms 2020, 8, 1797. [Google Scholar] [CrossRef]
- Rastogi, N.; Mathur, P. Ochrobactrum Anthropi: An Emerging Pathogen Causing Meningitis with Sepsis in a Neurotrauma Patient. J. Infect. Dev. Ctries. 2017, 11, 733–735. [Google Scholar] [CrossRef]
- Thoma, B.; Straube, E.; Scholz, H.C.; Al Dahouk, S.; Zöller, L.; Pfeffer, M.; Neubauer, H.; Tomaso, H. Identification and Antimicrobial Susceptibilities of Ochrobactrum Spp. Int. J. Med. Microbiol. 2009, 299, 209–220. [Google Scholar] [CrossRef]
- Higgins, C.S.; Avison, M.B.; Jamieson, L.; Simm, A.M.; Bennett, P.M.; Walsh, T.R. Characterization, Cloning and Sequence Analysis of the Inducible Ochrobactrum Anthropi AmpC β-Lactamase. J. Antimicrob. Chemother. 2001, 47, 745–754. [Google Scholar] [CrossRef] [PubMed]
- Shanthini, T.; Manohar, P.; Samna, S.; Srividya, R.; Bozdogan, B.; Rameshpathy, M.; Ramesh, N. Emergence of Plasmid-Borne Blaoxa-181 Gene in Ochrobactrum Intermedium: First Report from India. Access Microbiol. 2019, 1, e000024. [Google Scholar] [CrossRef]
- Chen, Y.; Liao, K.; Ai, L.; Guo, P.; Huang, H.; Wu, Z.; Liu, M. Bacteremia Caused by Bergeyella Zoohelcum in an Infective Endocarditis Patient: Case Report and Review of Literature. BMC Infect. Dis. 2017, 17, 271. [Google Scholar] [CrossRef] [PubMed]
- Grams, T.R.; Kim, D.Y.; McElvania, E. The Brief Case: Bergeyella Zoohelcum Bacteremia in an Immunocompromised 69-Year-Old Patient. J. Clin. Microbiol. 2023, 61, e00408-22. [Google Scholar] [CrossRef]
- Reina, J.; Borrell, N. Leg Abscess Caused by Weeksella Zoohelcum Following a Dog Bite. Clin. Infect. Dis. 1992, 14, 1162–1163. [Google Scholar] [CrossRef]
- Montejo, M.; Aguirrebengoa, K.; Ugalde, J.; Lopez, L.; Nieto, J.A.S.; Hernández, J.L. Bergeyella Zoohelcum Bacteremia after a Dog Bite. Clin. Infect. Dis. 2001, 33, 1608–1609. [Google Scholar] [CrossRef]
- de la Fuente García Peña, L.A.; Mendoza García, A.U.; Villegas-Dominguez, J.E.; Márquez Celedonio, F.G.; Arana Vidal, H.; Azuara Díaz, K. Ventilator-Associated Pneumonia by Weeksella Virosa: Case Report. BMC Infect. Dis. 2024, 24, 6. [Google Scholar] [CrossRef]
- Manogaran, M.; Marnejon, T.; Sarac, E. Pneumonia and Sepsis Due to Weeksella Virosa in an Immunocompromised Patient. Infect. Dis. Clin. Pract. 2004, 12, 286. [Google Scholar] [CrossRef]
- Vaquera-Aparicio, D.N.; Mascareñas-De los Santos, A.H.; Casillas-Vega, N.; Riojas-Hernández, P.; Llaca-Díaz, J.; Herrera-Benavente, I.; Castillo-Bejarano, J.I. Bacteremia Due to Weeksella Virosa in a Pediatric Patient with Embryonal Rhabdomyosarcoma. Boletín Médico Hosp. Infant. México 2020, 77, 149–152. [Google Scholar] [CrossRef]
- O’Rourke, D.P.; Rosenbaum, M.D. Chapter 18—Biology and Diseases of Amphibians. In Laboratory Animal Medicine, 3rd ed.; Fox, J.G., Anderson, L.C., Otto, G.M., Pritchett-Corning, K.R., Whary, M.T., Eds.; American College of Laboratory Animal Medicine; Academic Press: Boston, MA, USA, 2015; pp. 931–965. ISBN 978-0-12-409527-4. [Google Scholar]
- Jean, S.-S.; Hsieh, T.-C.; Ning, Y.-Z.; Hsueh, P.-R. Role of Vancomycin in the Treatment of Bacteraemia and Meningitis Caused by Elizabethkingia Meningoseptica. Int. J. Antimicrob. Agents 2017, 50, 507–511. [Google Scholar] [CrossRef]
- Mukerji, R.; Kakarala, R.; Smith, S.J.; Kusz, H.G. Chryseobacterium Indologenes: An Emerging Infection in the USA. BMJ Case Rep. 2016, 2016, bcr2016214486. [Google Scholar] [CrossRef] [PubMed]
- Kirby, J.T.; Sader, H.S.; Walsh, T.R.; Jones, R.N. Antimicrobial Susceptibility and Epidemiology of a Worldwide Collection of Chryseobacterium Spp.: Report from the SENTRY Antimicrobial Surveillance Program (1997–2001). J. Clin. Microbiol. 2004, 42, 445–448. [Google Scholar] [CrossRef]
- Ryan, M.P.; Sevjahova, L.; Gorman, R.; White, S. The Emergence of the Genus Comamonas as Important Opportunistic Pathogens. Pathogens 2022, 11, 1032. [Google Scholar] [CrossRef] [PubMed]
- Zhang, Y.; Li, K.; Zhan, Y.; Shi, L.; Zeng, Y.; Wang, H.; Lu, Z. Bacteremia Caused by Comamonas Kerstersii in a Patient with Acute Perforated Appendicitis and Localized Peritonitis: Case Report and Literature Review. Front. Med. 2023, 10, 1283769. [Google Scholar] [CrossRef]
- Højgaard, S.M.M.; Rezahosseini, O.; Knudsen, J.D.; Fuglebjerg, N.J.U.; Skov, M.; Nielsen, S.D.; Harboe, Z.B. Characteristics and Outcomes of Patients with Delftia Acidovorans Infections: A Retrospective Cohort Study. Microbiol. Spectr. 2022, 10, e0032622. [Google Scholar] [CrossRef] [PubMed]
- Lu, T.-L.; Huang, C. Retrospective Cohort Study on Delftia Acidovorans Infections in Patients: A Rare and Significant Infection. Infect. Drug Resist. 2024, 17, 1741–1749. [Google Scholar] [CrossRef]
- Orsborne, C.; Hardy, A.; Isalska, B.; Williams, S.G.; Muldoon, E.G. Acidovorax Oryzae Catheter-Associated Bloodstream Infection. J. Clin. Microbiol. 2014, 52, 4421–4424. [Google Scholar] [CrossRef]
- Farfour, E.; Vasse, M.; Vallée, A. Oligella Spp.: A Systematic Review on an Uncommon Urinary Pathogen. Eur. J. Clin. Microbiol. Infect. Dis. 2024, 43, 1037–1050. [Google Scholar] [CrossRef]
- Ziogou, A.; Giannakodimos, A.; Giannakodimos, I.; Tsantes, A.G.; Ioannou, P. Pandoraea Infections in Humans—A Systematic Review. J. Clin. Med. 2024, 13, 6905. [Google Scholar] [CrossRef]
- Lin, C.; Luo, N.; Xu, Q.; Zhang, J.; Cai, M.; Zheng, G.; Yang, P. Pneumonia Due to Pandoraea Apista after Evacuation of Traumatic Intracranial Hematomas:A Case Report and Literature Review. BMC Infect. Dis. 2019, 19, 869. [Google Scholar] [CrossRef]
- Kumaria, A.; Crusz, S.A.; Lister, M.; Kirkman, M.A.; Macarthur, D.C. Psychrobacter Piechaudii Shunt Infection: First Report of Human Infection. Childs Nerv. Syst. 2022, 38, 1385–1388. [Google Scholar] [CrossRef] [PubMed]
- Steyaert, S.; Peeters, C.; Wieme, A.D.; Muyldermans, A.; Vandoorslaer, K.; Spilker, T.; Wybo, I.; Piérard, D.; LiPuma, J.J.; Vandamme, P. Novel Ralstonia Species from Human Infections: Improved Matrix-Assisted Laser Desorption/Ionization Time-of-Flight Mass Spectrometry-Based Identification and Analysis of Antimicrobial Resistance Patterns. Microbiol. Spectr. 2024, 12, e04021-23. [Google Scholar] [CrossRef] [PubMed]
- Green, H.D.; Bright-Thomas, R.; Kenna, D.T.; Turton, J.F.; Woodford, N.; Jones, A.M. Ralstonia Infection in Cystic Fibrosis. Epidemiol. Infect. 2017, 145, 2864–2872. [Google Scholar] [CrossRef] [PubMed]
- Tiwari, S. Primary Bacteremia Caused by Rhizobium Radiobacter in Neonate: A Rare Case Report. J. Clin. Diagn. Res. JCDR 2015, 9, DD01. [Google Scholar] [CrossRef]
- Lai, C.; Teng, L.; Hsueh, P.; Yuan, A.; Tsai, K.; Tang, J.; Tien, H. Clinical and Microbiological Characteristics of Rhizobium Radiobacter Infections. Clin. Infect. Dis. 2004, 38, 149–153. [Google Scholar] [CrossRef]
- Müller, S.; Von Bonin, S.; Schneider, R.; Krüger, M.; Quick, S.; Schröttner, P. Shewanella Putrefaciens, a Rare Human Pathogen: A Review from a Clinical Perspective. Front. Cell. Infect. Microbiol. 2023, 12, 1033639. [Google Scholar] [CrossRef]
- Yu, K.; Huang, Z.; Xiao, Y.; Wang, D. Shewanella Infection in Humans: Epidemiology, Clinical Features and Pathogenicity. Virulence 2022, 13, 1515–1532. [Google Scholar] [CrossRef]
- Antonelli, A.; Di Palo, D.M.; Galano, A.; Becciani, S.; Montagnani, C.; Pecile, P.; Galli, L.; Rossolini, G.M. Intestinal Carriage of Shewanella Xiamenensis Simulating Carriage of OXA-48–Producing Enterobacteriaceae. Diagn. Microbiol. Infect. Dis. 2015, 82, 1–3. [Google Scholar] [CrossRef]
- Zong, Z. Nosocomial Peripancreatic Infection Associated with Shewanella Xiamenensis. J. Med. Microbiol. 2011, 60, 1387–1390. [Google Scholar] [CrossRef]
- Holt, H.M.; Gahrn-Hansen, B.; Bruun, B. Shewanella Algae and Shewanella Putrefaciens: Clinical and Microbiological Characteristics. Clin. Microbiol. Infect. 2005, 11, 347–352. [Google Scholar] [CrossRef]
- Grimaldi, D.; Doloy, A.; Fichet, J.; Bourgeois, E.; Zuber, B.; Wajsfisz, A.; Mira, J.P.; Poyart, C.; Pène, F. Necrotizing Fasciitis and Septic Shock Related to the Uncommon Gram-Negative Pathogen Sphingobacterium Multivorum. J. Clin. Microbiol. 2012, 50, 202–203. [Google Scholar] [CrossRef] [PubMed]
- Barahona, F.; Slim, J. Sphingobacterium Multivorum: Case Report and Literature Review. New Microbes New Infect. 2015, 7, 33–36. [Google Scholar] [CrossRef] [PubMed]
- Fass, R.J.; Bamishan, J. In Vitro Susceptibilities of Nonfermentative Gram-Negative Bacilli Other than Pseudomonas Aeruginosa to 32 Antimicrobial Agents. Clin. Infect. Dis. 1980, 2, 841–853. [Google Scholar] [CrossRef] [PubMed]
- Blahová, J.; Králiková, K.; Krčméry, V.; Kuboňová, K. Hydrolysis of Imipenem, Meropenem, Ceftazidime, and Cefepime by Multiresistant Nosocomial Strains ofSphingobacterium Multivorum. Eur. J. Clin. Microbiol. Infect. Dis. 1997, 16, 178–180. [Google Scholar] [CrossRef]

| Type of Resistant Mechanism | Antibiotics Affected | Reference |
|---|---|---|
| Multidrug Efflux Pumps | [32,41] | |
| AxyABM | Cephalosporins (except cefuroxime and FEP), AZT and chloramphenicol | |
| AxyXY-OprZ | AMG, TET, TG, FQ, FEP, carbapenems | |
| β-Lactamases | [32] | |
| OXA-114-like | Piperacillin, ticarcillin, benzylpenicillin, cephalothin | |
| ESBL and AmpC | All β-lactams except carbapenems | |
| Metallo-β-lactamases | All β-lactams except AZT | |
| Other mechanisms | [32,42] | |
| aac(6′)Ib-cr, qnrA, oqxA, oqxB | FQ, AMG | |
| gyrA, ParC | FQ | |
| Biofilm | β-lactams and AMG |
| Type of Resistant Mechanism | Antibiotics Affected | Reference |
|---|---|---|
| Class A β-lactamases (gene penA, penB and penR) | Mutations lead to CAZ resistance, IMP, A/C | [59] |
| The efflux pump system of the resistance nodulation cell division | Intrinsic resistance to penicillin, first and second-generation cephalosporins, gentamycin, tobramycin, streptomycin, polymyxin | [91,96,105] |
| Reduced outer membrane permeability/modified LPS structure | Polymixin | [59] |
| Alteration in drug targets | Mutations affecting topoisomerases type II enzymes, DNA gyrase, and topoisomerases type IV leads to FQ resistance. Mutations in the dihydrofolate reductase led to SXT resistance | [59,106,107] |
| Biofilm | Unlike planktonic organisms, B. pseudomallei biofilm production is associated with resistance to multiple antimicrobials, including CAZ, IMP, SXT | [108,109] |
| Microorganism | Mild to Moderate Disease | Sever Disease * | References |
|---|---|---|---|
| Achromobacter xylosoxidans | No prior antibiotic exposure
| No prior antibiotic exposure
| [32,49] |
| Alcaligenes faecalis |
| No prior antibiotic exposure
| [51,53] |
| Burkholderia cepacia complex |
| No prior antibiotic exposure
| [48,71,72,73,74,75] |
| Burkholderia pseudomallei complex | IV initial therapy
| [89,94] | |
| Burkholderia gladioli |
| No prior antibiotic exposure
| [111] |
| Elizabethkingia meningoseptica |
| No prior antibiotic exposure
| [124,125,126] |
| Moraxella catharallis |
| [149,150,151,152] | |
| Ochrobactrum spp. |
| [155,157] | |
| Bergeyella spp. |
| [160,162,163] | |
| Weeksella virosa |
| [164,166] | |
| Chryseobacterium spp. |
| [170] | |
| Comamonas spp. |
| [171] | |
| Delftia acidovorans |
| [173,174] | |
| Acidovorax spp. |
| [175] | |
| Oligella spp. |
| [176] | |
| Pandoraea spp. |
| [177] | |
| Ralstonia spp. |
| [180,181] | |
| Rhizobium spp. |
| [19] | |
| Shewanella spp. |
| [19] | |
| Sphingobacterium spp. |
| [190,192] | |
Disclaimer/Publisher’s Note: The statements, opinions and data contained in all publications are solely those of the individual author(s) and contributor(s) and not of MDPI and/or the editor(s). MDPI and/or the editor(s) disclaim responsibility for any injury to people or property resulting from any ideas, methods, instructions or products referred to in the content. |
© 2025 by the authors. Licensee MDPI, Basel, Switzerland. This article is an open access article distributed under the terms and conditions of the Creative Commons Attribution (CC BY) license (https://creativecommons.org/licenses/by/4.0/).
Share and Cite
Geremia, N.; Marino, A.; De Vito, A.; Giovagnorio, F.; Stracquadanio, S.; Colpani, A.; Di Bella, S.; Madeddu, G.; Parisi, S.G.; Stefani, S.; et al. Rare or Unusual Non-Fermenting Gram-Negative Bacteria: Therapeutic Approach and Antibiotic Treatment Options. Antibiotics 2025, 14, 306. https://doi.org/10.3390/antibiotics14030306
Geremia N, Marino A, De Vito A, Giovagnorio F, Stracquadanio S, Colpani A, Di Bella S, Madeddu G, Parisi SG, Stefani S, et al. Rare or Unusual Non-Fermenting Gram-Negative Bacteria: Therapeutic Approach and Antibiotic Treatment Options. Antibiotics. 2025; 14(3):306. https://doi.org/10.3390/antibiotics14030306
Chicago/Turabian StyleGeremia, Nicholas, Andrea Marino, Andrea De Vito, Federico Giovagnorio, Stefano Stracquadanio, Agnese Colpani, Stefano Di Bella, Giordano Madeddu, Saverio Giuseppe Parisi, Stefania Stefani, and et al. 2025. "Rare or Unusual Non-Fermenting Gram-Negative Bacteria: Therapeutic Approach and Antibiotic Treatment Options" Antibiotics 14, no. 3: 306. https://doi.org/10.3390/antibiotics14030306
APA StyleGeremia, N., Marino, A., De Vito, A., Giovagnorio, F., Stracquadanio, S., Colpani, A., Di Bella, S., Madeddu, G., Parisi, S. G., Stefani, S., & Nunnari, G. (2025). Rare or Unusual Non-Fermenting Gram-Negative Bacteria: Therapeutic Approach and Antibiotic Treatment Options. Antibiotics, 14(3), 306. https://doi.org/10.3390/antibiotics14030306

